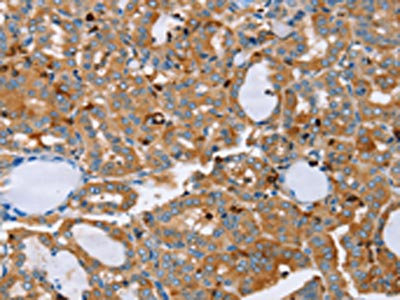

PLS3 Antibody
-
中文名稱:PLS3兔多克隆抗體
-
貨號:CSB-PA241730
-
規格:¥1100
-
圖片:
-
The image on the left is immunohistochemistry of paraffin-embedded Human thyroid cancer tissue using CSB-PA241730(PLS3 Antibody) at dilution 1/20, on the right is treated with fusion protein. (Original magnification: ×200)
-
The image on the left is immunohistochemistry of paraffin-embedded Human breast cancer tissue using CSB-PA241730(PLS3 Antibody) at dilution 1/20, on the right is treated with fusion protein. (Original magnification: ×200)
-
Gel: 6%SDS-PAGE, Lysate: 50 μg, Lane: Raji cells, Primary antibody: CSB-PA241730(PLS3 Antibody) at dilution 1/200, Secondary antibody: Goat anti rabbit IgG at 1/8000 dilution, Exposure time: 40 seconds
-
-
其他:
產品詳情
-
Uniprot No.:
-
基因名:PLS3
-
別名:BMND18 antibody; Plastin 3 (T isoform) antibody; Plastin 3 antibody; Plastin-3 antibody; PLS3 antibody; PLST_HUMAN antibody; T fimbrin antibody; T-plastin antibody
-
宿主:Rabbit
-
反應種屬:Human,Mouse,Rat
-
免疫原:Fusion protein of Human PLS3
-
免疫原種屬:Homo sapiens (Human)
-
標記方式:Non-conjugated
-
抗體亞型:IgG
-
純化方式:Antigen affinity purification
-
濃度:It differs from different batches. Please contact us to confirm it.
-
保存緩沖液:-20°C, pH7.4 PBS, 0.05% NaN3, 40% Glycerol
-
產品提供形式:Liquid
-
應用范圍:ELISA,WB,IHC
-
推薦稀釋比:
Application Recommended Dilution ELISA 1:1000-1:2000 WB 1:500-1:2000 IHC 1:25-1:100 -
Protocols:
-
儲存條件:Upon receipt, store at -20°C or -80°C. Avoid repeated freeze.
-
貨期:Basically, we can dispatch the products out in 1-3 working days after receiving your orders. Delivery time maybe differs from different purchasing way or location, please kindly consult your local distributors for specific delivery time.
-
用途:For Research Use Only. Not for use in diagnostic or therapeutic procedures.
相關產品
靶點詳情
-
功能:Actin-bundling protein found in intestinal microvilli, hair cell stereocilia, and fibroblast filopodia. May play a role in the regulation of bone development.
-
基因功能參考文獻:
- PLS3 deletions lead to severe childhood-onset osteoporosis resulting from defective bone matrix mineralization. PMID: 28777485
- PLS3 sequencing in childhood-onset primary osteoporosis identifies two novel disease-causing variants. PMID: 28748388
- T-plastin mediates the hypoxia-induced membrane trafficking PMID: 28218996
- PLS3 mutation plays a role in low turnover osteoporosis pathophysiology. PMID: 28379384
- Patients with PLS3 mutation-related osteoporosis respond to teriparatide treatment. PMID: 27732335
- We show that genes of the classical apoptosis pathway are involved in the smn-1-mediated neuronal death, and that this phenotype can be rescued by the expression of human SMN1, indicating a functional conservation between the two orthologs. Finally, we determined that Plastin3/plst-1 genetically interacts with smn-1 to prevent degeneration, and that treatment with valproic acid is able to rescue the degenerative phenotype PMID: 27260405
- PLS3 expression does not always modify SMA phenotype PMID: 27279027
- findings emphasize the power of genetic modifiers, PLS3 and CORO1C, to unravel the cellular pathomechanisms underlying spinal muscular atrophy (SMA)--and the power of combinatorial therapy based on splice correction of SMN2 and endocytosis improvement to efficiently treat SMA PMID: 27499521
- t is beyond doubt that PL S3 must be further investigated to determine its role in diagnostics, prediction, treatment and monitoring of treatment of colorectal cancer. PMID: 26146096
- PLS3 is a genuine spinal muscular atrophy protective modifier in SMN1-deleted individuals PMID: 26573968
- Measurements of SMN and PLS3 transcript and protein levels in induced pluripotent stem cell-derived motor neurons show limited value as Spinal muscular atrophy biomarkers. PMID: 26114395
- High levels of recombinant hPLS3 mRNA were expressed in motor neurons of SMA mice and an increased level of PLS3 protein in total spinal cord, yet neither survival nor the fundamental electrophysiological aspects of the neuromuscular junction improved. PMID: 26134627
- results confirm the role of PLS3 mutations in early onset osteoporosis. The mechanism whereby PLS3 affects bone health is unclear, but it may be linked to osteocyte dendrite function and skeletal mechanosensing PMID: 25209159
- plastin 3 is a regulator of actin microfilament bundles at the ES in which it dictates the configuration of the filamentous actin network PMID: 26048141
- PLS3 was expressed in circulating tumor cells undergoing the epithelial-mesenchymal transition in patients with breast cancer; an excellent biomarker for identifying groups at risk of recurrence or with a poor prognosis PMID: 25880010
- PLS3 overexpression is associated with colorectal cancer. PMID: 24217791
- T-plastin expression downstream to the calcineurin/NFAT pathway is involved in keratinocyte migration. PMID: 25226517
- Data suggest that several single-nucleotide polymorphisms (SNPs) of the plastin genes PLS3 and LCP1 could serve as gender- and/or stage-specific molecular predictors of tumor recurrence in stage II/III colorectal cancer as well as therapeutic targets. PMID: 24170770
- Loss of PLS3 is associated with spinal muscular atrophy. PMID: 24271012
- PLS3 expression and SMA phenotype: a commentary on correlation of PLS3 expression with disease severity in children with spinal muscular atrophy. PMID: 24284364
- PLS3 gene may have an age- and gender-specific role in the clinical severity of SMA in children afflicted with this condition. PMID: 24172247
- Plastin 3 (PLS3) appears to be important in human bone health, on the basis of pathogenic variants in PLS3 in five families with X-linked osteoporosis and osteoporotic fractures that we report here. PMID: 24088043
- study identified a common gene variant in PLS3 as an independent prognostic marker in female patients with stage II and III colon cancer PMID: 23549633
- PLS3 over-expression led to a stabilization of axons which, in turn, results in a significant delay of axon pruning, counteracting poor axonal connectivity in spinal muscular atrophy neuromuscular junctions. PMID: 23263861
- Overexpression of PLS3 is associated with epithelial-mesenchymal transition and is associated with metastasis in colorectal cancer PMID: 23378342
- PLS3, Twist, KIR3DL2 and NKp46 gene expression can model efficient molecular Sezary syndrome diagnosis. PMID: 23429988
- PLS3 is expressed in the majority of SS patients and provide insight into the molecular regulation of PLS3 expression in CTCL PMID: 22495182
- T-plastin is a marker restricted to malignant lymphocytes from Sezary syndrome patients and plays a role for cell survival and migration. PMID: 22627769
- The PLS3 gene may be an age- and/or puberty-specific and sex-specific modifier of spinal muscular atrophy. PMID: 20937953
- expression of T-plastin in the placental context may indeed be associated with the enhanced replicative potential of placental trophoblasts. PMID: 14567899
- T-plastin has the potential to be a Sezary cell-specific marker valuable for diagnostic and treatment of Sezary syndrome. PMID: 14612505
- T-plastin increases Arp2/3-mediated actin-based movement PMID: 15741236
- T-fimbrin has a role in the response to DNA damage PMID: 16142308
- unaffected SMN1-deleted females exhibit significantly higher expression of PLS3 than their spinal muscular atrophy-affected counterparts PMID: 18440926
- Increased T-plastin is associated with leukemic cutaneous T-cell lymphoma PMID: 18569641
顯示更多
收起更多
-
相關疾病:Osteoporosis (OSTEOP)
-
亞細胞定位:Cytoplasm.
-
組織特異性:Expressed in a variety of organs, including muscle, brain, uterus and esophagus.
-
數據庫鏈接:
Most popular with customers
-
-
YWHAB Recombinant Monoclonal Antibody
Applications: ELISA, WB, IHC, IF, FC
Species Reactivity: Human, Mouse, Rat
-
Phospho-YAP1 (S127) Recombinant Monoclonal Antibody
Applications: ELISA, WB, IHC
Species Reactivity: Human
-
-
-
-
-